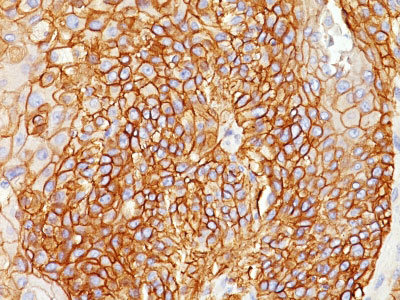

> Antigen, Antibodies, ELISA, Western Blot > Primary Antibody > Monoclonal Antibodies > EGFR (Epidermal Growth Factor Receptor) Antibody - Without BSA and AzideBrand |
Leading Biology | Catalog Number |
AMM00250G |
Product Type |
Monoclonal Antibodies | Field of Research |
|
Product Overview |
We constantly strive to ensure we provide our customers with the best antibodies. As a result of this work we offer this antibody in purified format.
We are in the process of updating our datasheets. If you have any questions regarding this update, please feel free to contact our technical support team.
This product is a high quality EGFR (Epidermal Growth Factor Receptor) Antibody - Without BSA and Azide.
|
||
Molecular Weight |
~170kDa (wild type) and ~145kDa (vIII variant)
|
||
Cellular Localization |
Antigen Cellular Localization:
Cell membrane; Single-pass type I membrane protein. Endoplasmic reticulum membrane; Single-pass type I membrane protein. Golgi apparatus membrane; Single-pass type I membrane protein. Nucleus membrane; Single-pass type I membrane protein. Endosome. Endosome membrane. Nucleus. Note=In response to EGF, translocated from the cell membrane to the nucleus via Golgi and ER. Endocytosed upon activation by ligand. Colocalized with GPER1 in the nucleus of estrogen agonist-induced cancer-associated fibroblasts (CAF)
|
||
Host |
Mouse
|
||
Species Reactivity |
Human
|
||
Clone |
GFR450
|
||
Isotype |
Mouse / IgG2a, kappa
|
||
Symbol |
ERBB, ERBB1, HER1
|
||
GeneID |
|||
UniProt ID |
|||
Function |
Receptor tyrosine kinase binding ligands of the EGF family and activating several signaling cascades to convert extracellular cues into appropriate cellular responses. Known ligands include EGF, TGFA/TGF-alpha, amphiregulin, epigen/EPGN, BTC/betacellulin, epiregulin/EREG and HBEGF/heparin-binding EGF. Ligand binding triggers receptor homo- and/or heterodimerization and autophosphorylation on key cytoplasmic residues. The phosphorylated receptor recruits adapter proteins like GRB2 which in turn activates complex downstream signaling cascades. Activates at least 4 major downstream signaling cascades including the RAS- RAF-MEK-ERK, PI3 kinase-AKT, PLCgamma-PKC and STATs modules. May also activate the NF-kappa-B signaling cascade. Also directly phosphorylates other proteins like RGS16, activating its GTPase activity and probably coupling the EGF receptor signaling to the G protein-coupled receptor signaling. Also phosphorylates MUC1 and increases its interaction with SRC and CTNNB1/beta-catenin.
|
||
Summary |
This MAb recognizes a protein of 170kDa, identified as EGFR. EGFR is type I receptor tyrosine kinase with sequence homology to erbB-1, -2, -3 -4 or HER-1, -2, -3 -4. It binds to Epidermal Growth Factor (EGF), Transforming Growth Factor-a (TGF-a), Heparin-binding EGF (HB-EGF), amphiregulin, βcellulin and epiregulin. EGFR is overexpressed in tumors of breast, brain, bladder, lung, gastric, head & neck, esophagus, cervix, vulva, ovary, and endometrium. It is predominantly present in squamous cell carcinomas.
|
||
Form |
Liquid. Purified antibody supplied in 1x PBS buffer with 0.09% (w/v) sodium azide and 2% sucrose. |
||
Storage & Stability |
Store at +4°C short term. For long-term storage, aliquot and store at -20°C or below. Stable for 12 months at -20°C. Avoid repeated freeze-thaw cycles.
|
||
Applications |
IHC-P, IF, FC
|
||
Images |
Formalin-fixed, paraffin-embedded Lung Squamous Cell Carcinoma stained with EGFR Monoclonal Antibody (GFR450). 
Flow Cytometry of human EGFR on A431 Cells.Black: Cells alone; Grey: Isotype Control; Green: AF488-labeled EGFR Monoclonal Antibody (GFR450). 
Confocal Immunofluorescent analysis of A431 cells using AF488-labeled EGFR Monoclonal Antibody (GFR450) (Green). DAPI was used to stain the cell nuclei (blue). |
||
Specification |
|||
Quantity |
|
||
| Select | Brand | Catalog No. | Product Name | Pack Size | Type | Field of Research | Specification | Quantity | Price(USD) | |
| 1 | Leading Biology | APG02467G | CCK4 / PTK7 Antibody (clone 4F9) | 50 μl | Monoclonal Antibodies |
|
$495.00 | Add Ask | ||
| 2 | Leading Biology | AMM04683G | GALT Antibody (clone 4C11) | 50 μg | Monoclonal Antibodies |
|
$545.00 | Add Ask | ||
| 3 | Leading Biology | AMM01402G | Vimentin (Mesenchymal Cell Marker) Antibody - With BSA and Azide | 50 ug | Monoclonal Antibodies |
|
$395.00 | Add Ask | ||
| 4 | Leading Biology | APR08280G | LTA4H / LTA4 Antibody (clone 9G8) | 50 μl | Monoclonal Antibodies |
|
$495.00 | Add Ask | ||
| 5 | Leading Biology | AMM00172G | CD1a / HTA1 (Mature Langerhans Cells Marker) Antibody - With BSA and Azide | 50 ug | Monoclonal Antibodies |
|
$395.00 | Add Ask | ||
| 6 | Leading Biology | AMM05750G | CEBPA Antibody | 100 μl | Monoclonal Antibodies |
|
$545.00 | Add Ask |
 Leading Biology Inc.
2600 Hilltop DR, Building G, B Suite C138
Richmond, CA, 94806
Tel: 1-661-524(LBI)-0262
Email: info@leadingbiology.com
Leading Biology Inc.
2600 Hilltop DR, Building G, B Suite C138
Richmond, CA, 94806
Tel: 1-661-524(LBI)-0262
Email: info@leadingbiology.com
Complete this form and click send to ask us a question, request a quote or simply say hello.

You have 0 item in your cart

You have 0 item in your inquiry list
